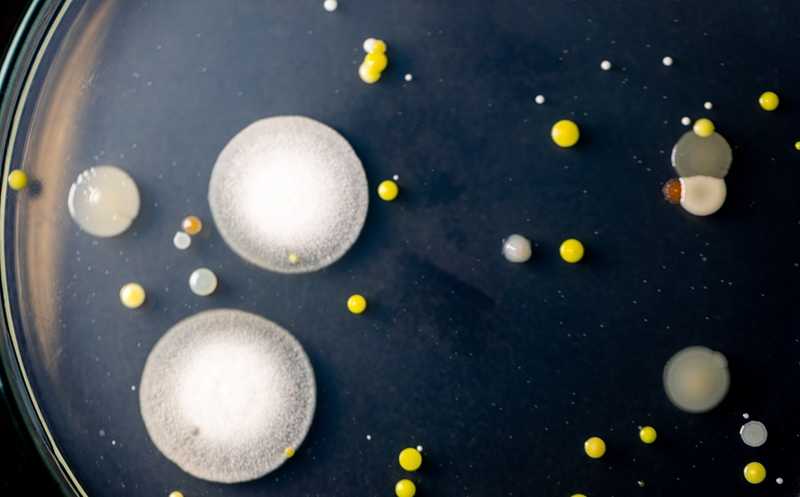

Микробиом метастазов влияет на эффективность иммунотерапии
Эффективность терапии может зависеть от бактерий, находящихся в микроокружении опухоли или внутри опухолевых клеток. Ученые из Нидерландов представили атлас микробиомов более 4 тысяч метастазов, относящихся к 26 типам первичных опухолей. Оказалось, что микробиом метастазов в определенных случаях способствует образованию иммуносупрессивного опухолевого микроокружения. Поэтому состав микробиома может указывать на потенциальную эффективность иммунотерапии.
Состав микробиома первичных опухолей значительно отличается от здоровых тканей. Бактерии могут находиться внутри опухолевых клеток, из-за чего их пептиды презентуются в составе комплексов с HLA-I и HLA-II. Также микробиом иногда влияет на опухолевое микроокружение, что, в свою очередь, может определять эффективность терапии, особенно иммунотерапии. Особый интерес представляет анализ метастазов, поскольку именно они в большинстве случаев являются причиной гибели при раке, на борьбу с ними чаще всего направлена терапия. Нидерландские ученые опубликовали исследование микробиома метастазов.
Авторы проанализировали образцы биопсии 4160 метастазов, относящихся к 26 типам первичных опухолей. Образцы были получены из когорты Hartwig Medical Foundation (Нидерланды). С помощью метагеномики и транскриптомики ученые определили особенности микробиома метастазов, его влияние на экспрессию генов в опухолевых клетках и на эффективность иммунотерапии ингибиторами контрольных точек иммунного ответа.
Всего ученые выявили 165 родов бактерий, 49% из которых были грамотрицательными, а 68% — анаэробами либо факультативными анаэробами. Они выяснили, что на состав микробиома метастазов в большей степени влияло анатомическое расположение метастаза, а не тип первичной опухоли. Анализ транскриптомных данных показал, что бактерии-анаэробы чаще встречались в гипоксических опухолях. Исследователи подтвердили эту находку, дополнительно проанализировав когорту из 31 пациента с опухолями головы и шеи, где анаэробные бактерии тоже чаще были сосредоточены в гипоксических опухолях. Эти данные не позволяют точно сказать, влияют ли анаэробы на формирование гипоксии в опухолевом микроокружении или такие условия просто являются более подходящими для их жизни.
Состав микробиома метастазов оказался связан с биологическими свойствами опухолевых клеток. Так, более высокое разнообразие бактерий в опухолевом микроокружении приводило к активации экспрессии генов, связанных с сигнальными путями EGFR, TGF-β и TNF-α. Последние два пути активируются антигенами бактерий. Также повышенное разнообразие бактерий влияло на организацию внеклеточного матрикса и на экспрессию антимикробных пептидов. Ученые предположили, что бактерии могут влиять на изменение структуры внеклеточного матрикса, чтобы обеспечить себе более комфортные условия для выживания.
Микробиом метастазов также влиял на опухолевый иммунитет. Так, внутриклеточные бактерии приводили к активации врожденного иммунитета. В частности, присутствие липополисахаридов бактерий было ассоциировано с экспрессией рецептора TLR4. Также микробиом влиял на поведение иммунных клеток. Он способствовал инфильтрации фибробластов, ассоциированных с опухолью, а также иммунной эксклюзии, то есть микробиом метастазов способствовал формированию иммунносупрессивной среды. Также в окружении метастазов, обладающих более разнообразным микробиомом, были обнаружены нейтрофилы, естественные киллеры, макрофаги и регуляторные Т-лимфоциты. Присутствие нейтрофилов в опухолевом окружении ученым показалось особенно интересным. В ходе нетоза эти клетки выбрасывают внеклеточные ловушки из ДНК, которыми захватывают патогены. Однако такие внеклеточные ловушки выступают «щитом» для опухолевых клеток, который защищает их от цитотоксического действия других иммунных клеток.
Исследователи дополнительно проанализировали 185 пар биопсий метастазов (всего 370 биопсий от 173 пациентов), которые отбирались с медианным промежутком 7,5 месяцев. Они подтвердили, что состав микробиома метастазов со временем остается относительно стабильным. Используя те же данные, ученые оценили влияние различных видов терапии на состав микробиома метастазов. Они сравнили разнообразие микробиома до и после применения иммунотерапии (33 образца), таргетной терапии (34 образца) или гормональной терапии (19 образцов). Разнообразие микробиома метастазов значительно снижалось только у пациентов, которые получали иммунотерапию ингибиторами контрольных точек иммунного ответа. Это было ассоциировано с благоприятным ответом на терапию. У пациентов, которые хорошо отвечали на такую иммунотерапию, в микробиоме метастазов реже встречались бактерии родов Actinomyces, Bifidobacterium, Prevotella.
Хуже ответ на ингибиторы контрольных точек иммунного ответа был у тех пациентов, в микробиоме метастазов которых преобладали бактерии рода Fusobacterium. В опухолевых клетках таких пациентов снижалась экспрессия генов MHC II, интерферона гамма, а также других генов, связанных с цитотоксической активностью. Это позволило ученым заключить, что Fusobacterium отрицательно влияют на эффективность иммунотерапии. Ранее эти грамотрицательные анаэробы уже были ассоциированы с прогрессией колоректального рака, а также было показано, что они могут напрямую подавлять активность лимфоцитов в опухоли.
Таким образом, ученые представили первый крупномасштабный атлас микробиомов метастазов, основанный на метагеномных и транскриптомных данных. Они считают, что этот атлас может стать полезным инструментом при поиске мишеней для воздействия в микробиомах метастазов.
Отдельные штаммы определяют ответ на иммунотерапию у пациентов с редкими раками
Источник:
Battaglia T., et al. A pan-cancer analysis of the microbiome in metastatic cancer. // Cell, 187 (2024). DOI: 10.1016/j.cell.2024.03.021


 Меню
Меню





 Все темы
Все темы




 0
0











